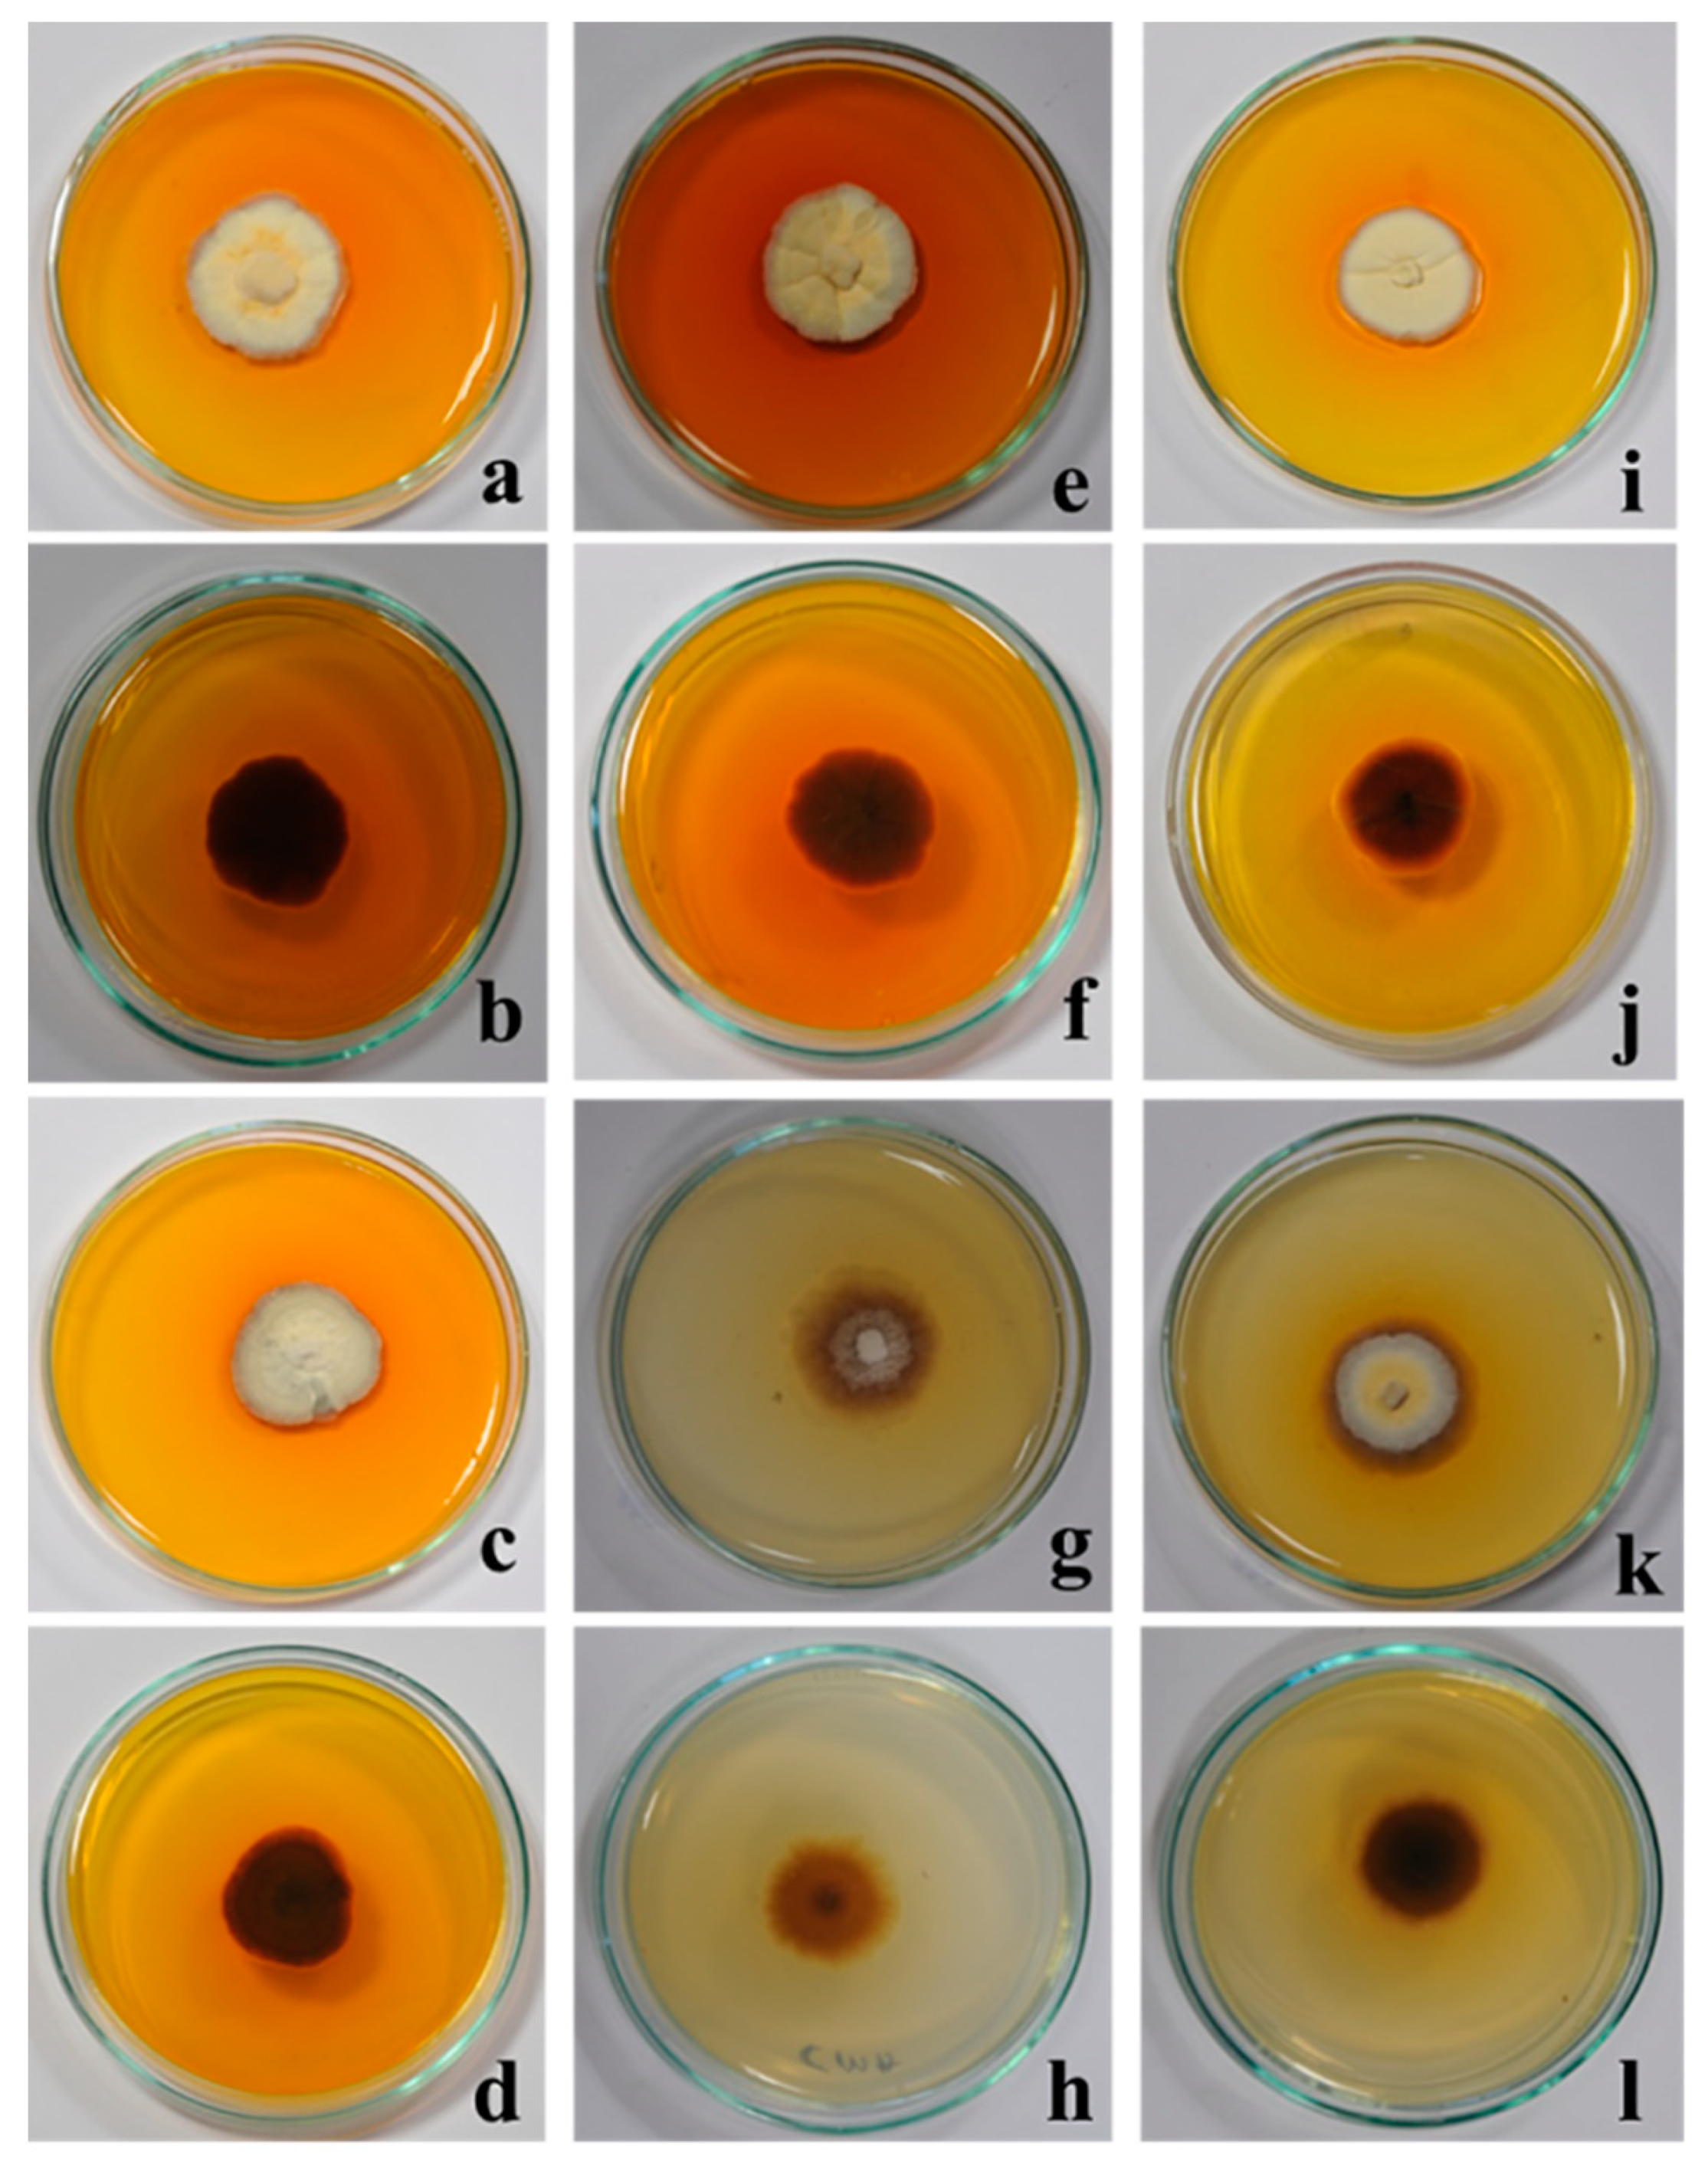
Molecules 27 00393 g003 550
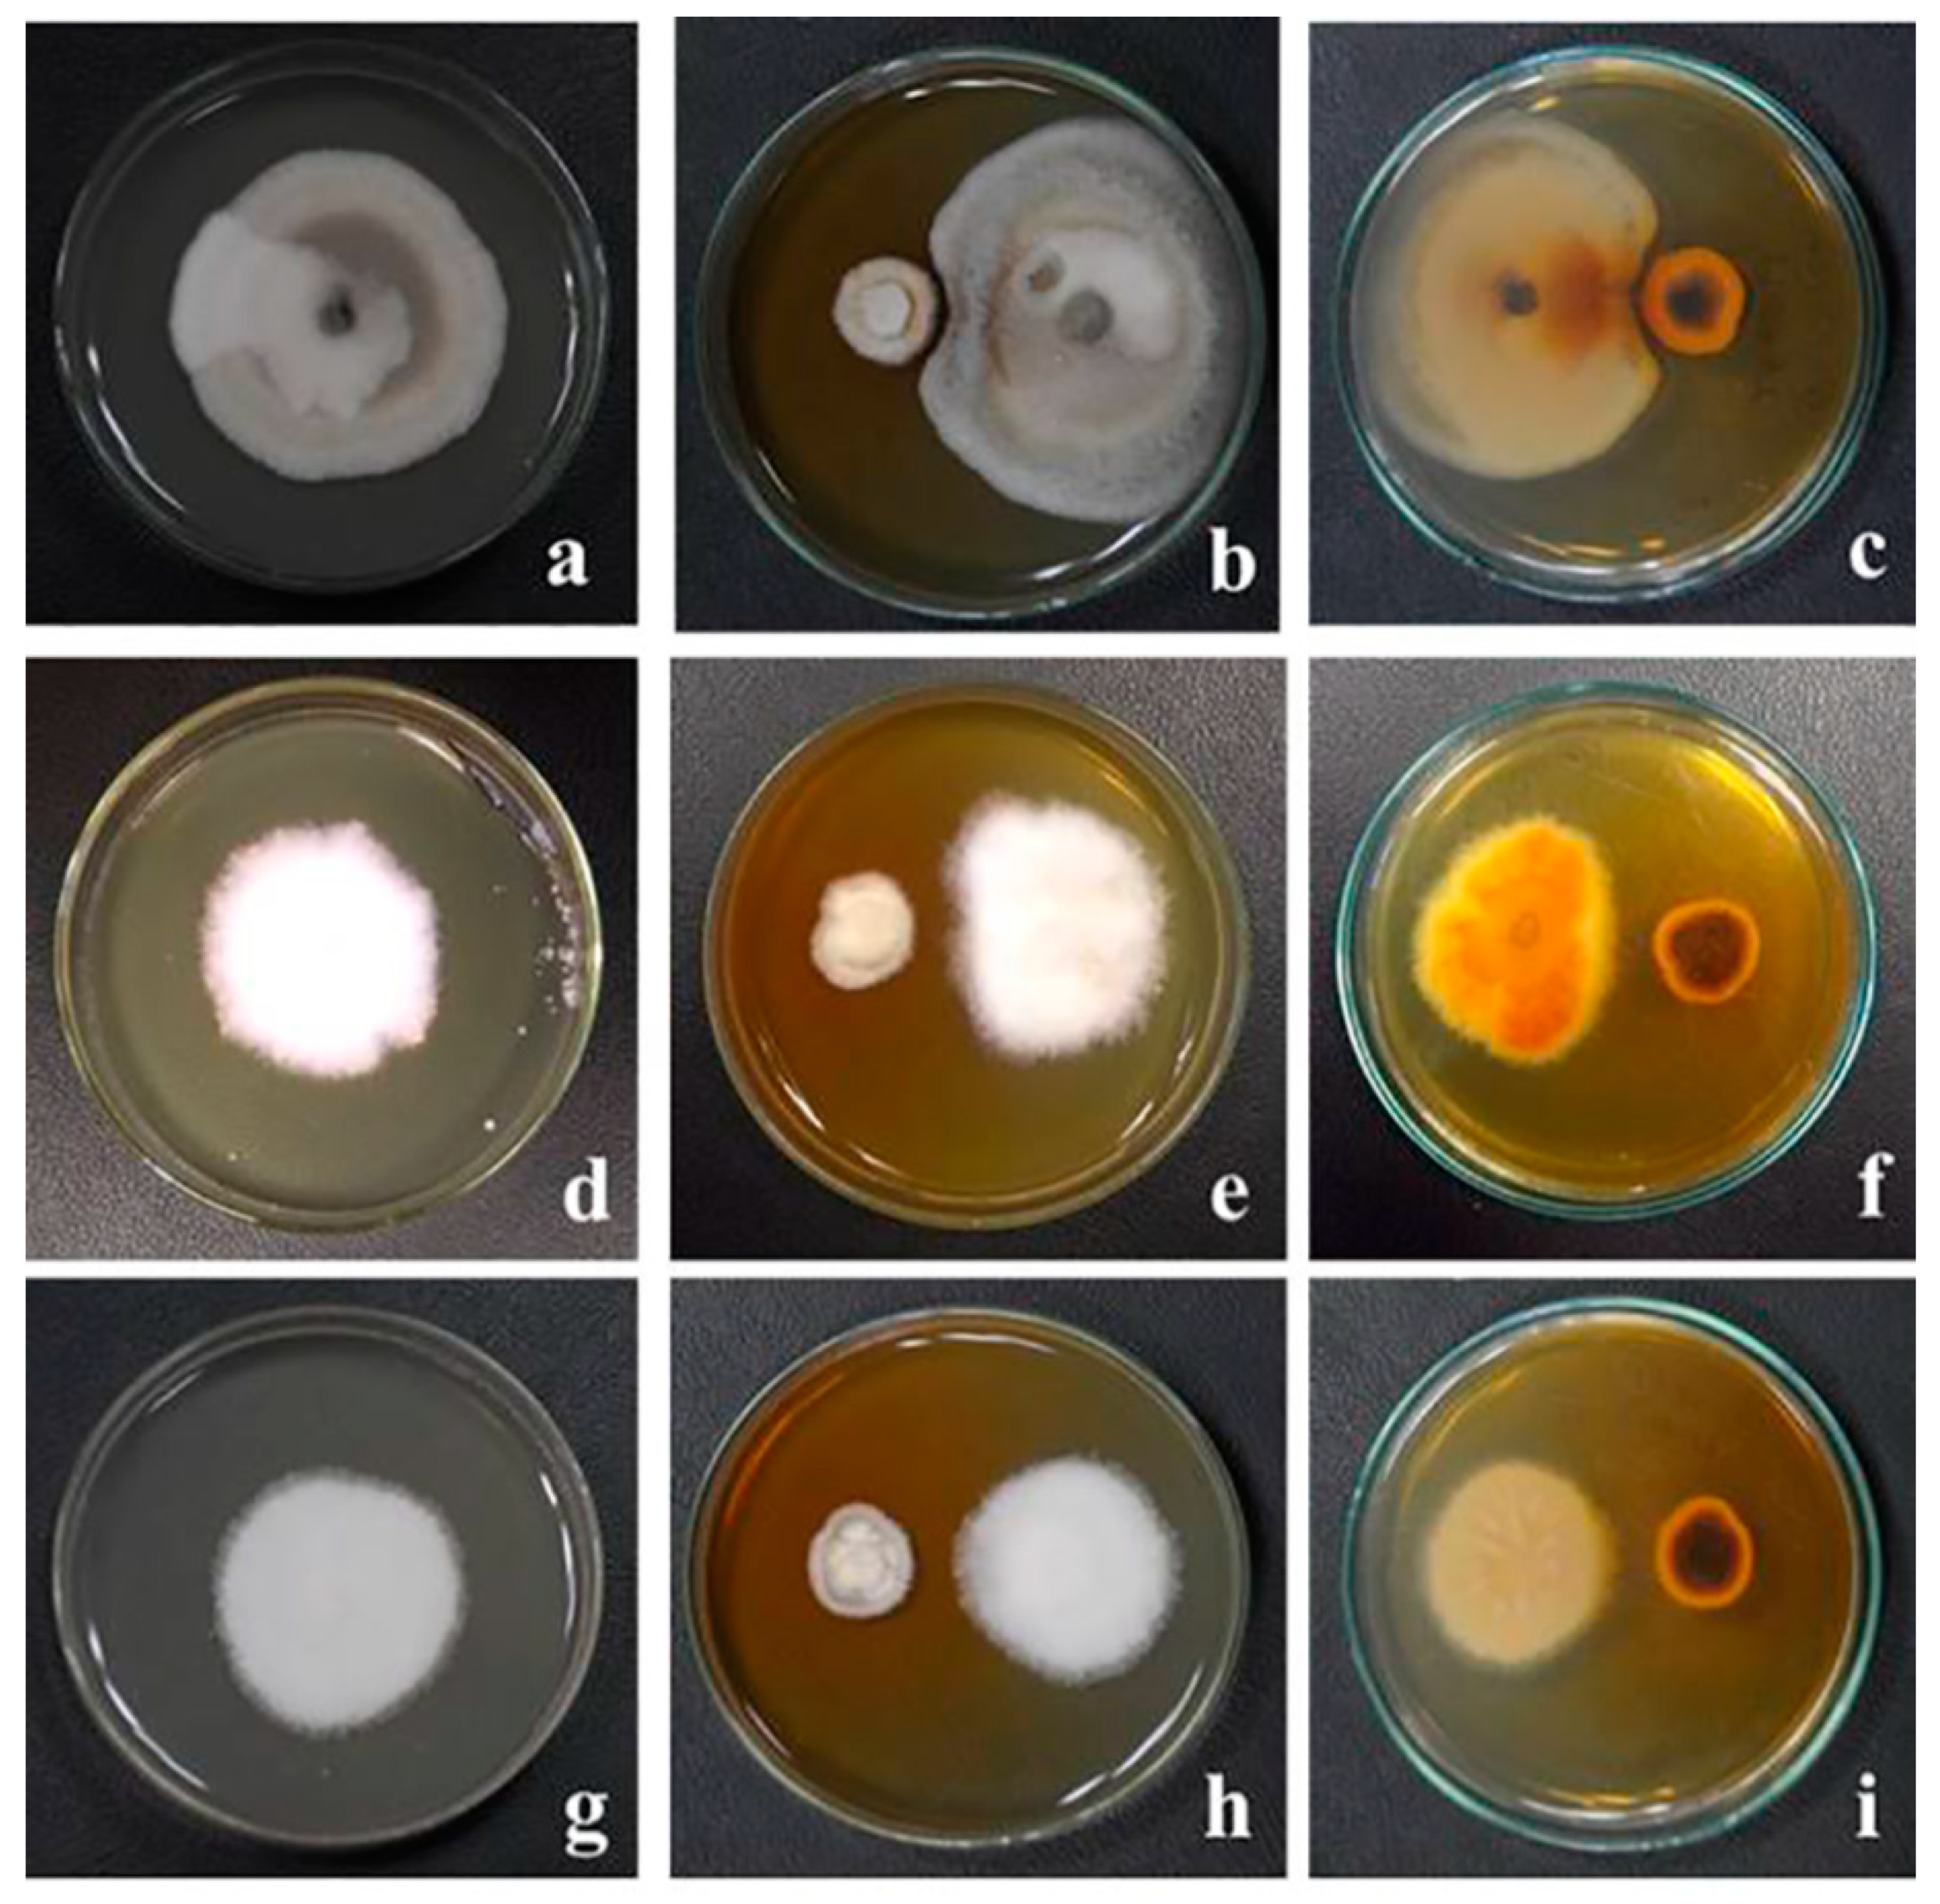
Molecules 27 00393 g008 550
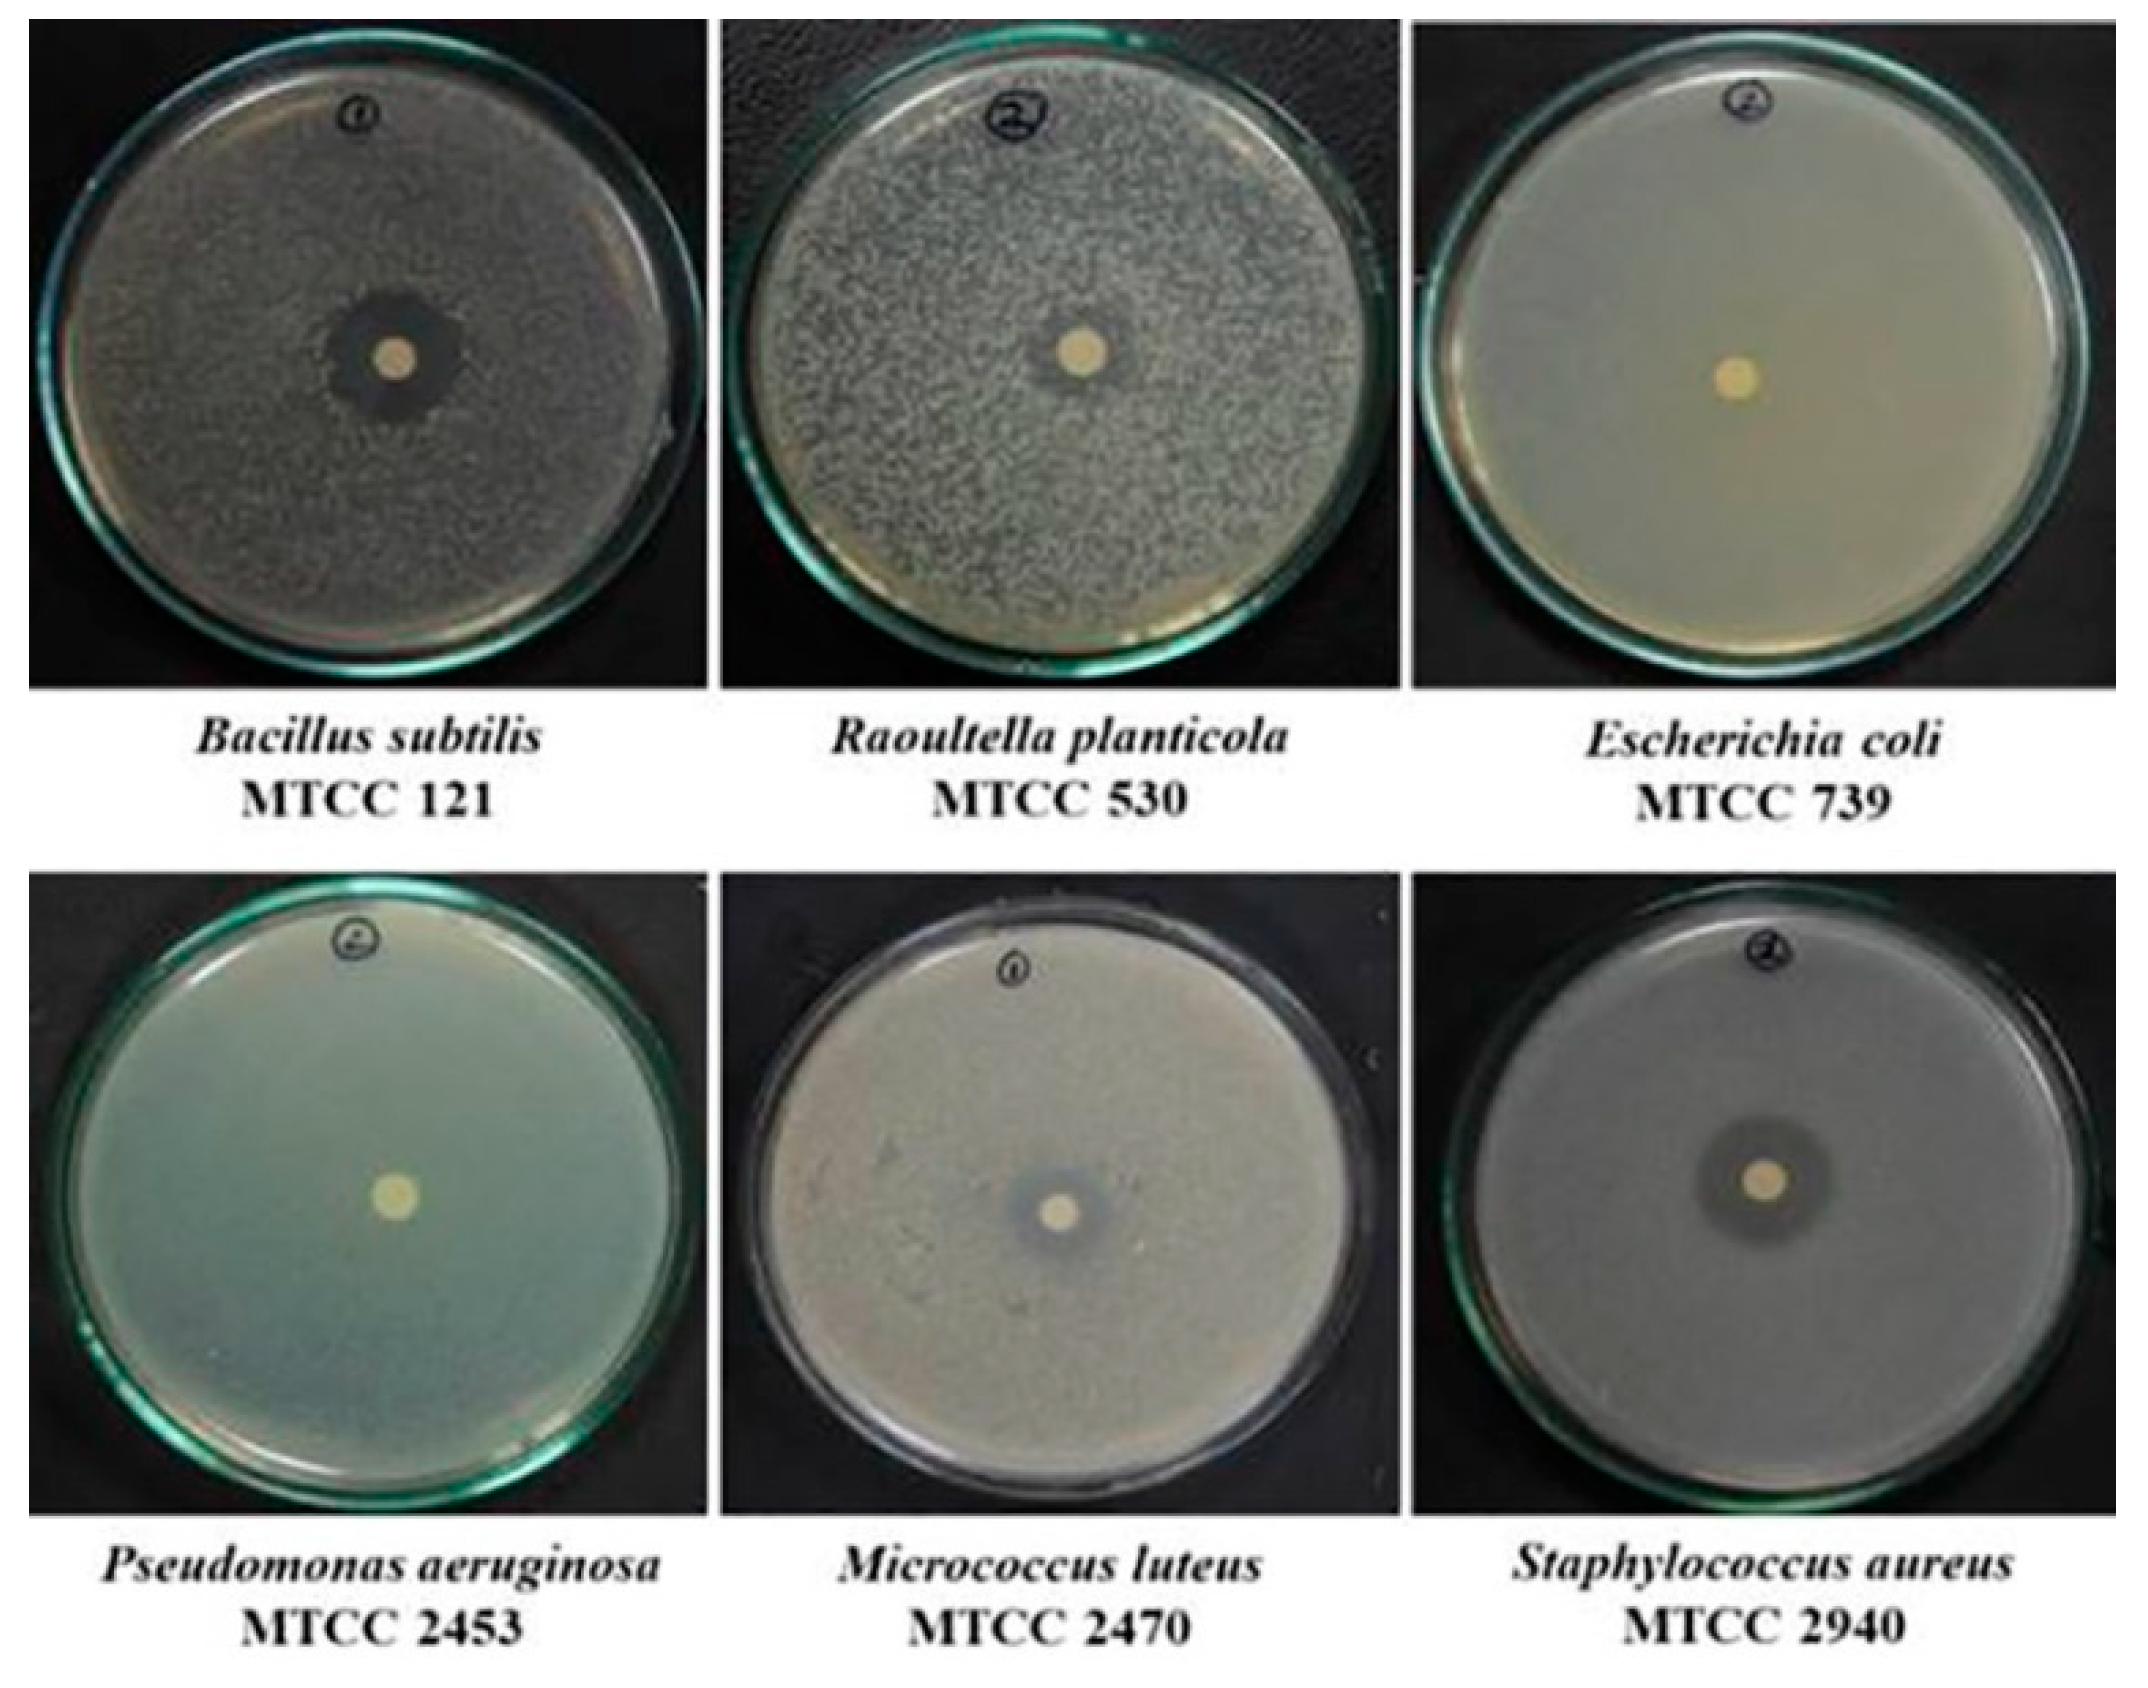
Molecules 27 00393 g010 550

Antioxidant, Antibacterial and Dyeing Potential of Crude Pigment Extract of Gonatophragmium triuniae and Its Chemical Characterization
Abstract
:1. Introduction
2. Results and Discussion
2.1. Morphological Identification
2.2. Molecular Identification and Phylogeny
2.3. Analysis of Pigment Production on Different Media
2.4. Pigment Production in Liquid Media
2.5. Fermentation and Extraction of Pigments
2.6. UV–Vis Spectroscopy Analysis of Hexane Extract
2.7. Antagonistic Activity Testing
2.8. Antioxidant Activity Testing of G. triuniae NFCCI 4873
2.9. Antimicrobial Activity Testing by Disc Diffusion
2.10. MIC and MBC of Crude Pigment
2.11. Dyeing of Cotton Fabric
2.12. GC-MS Analysis of Crude Hexane Extract
2.13. Purification of Pigment
2.14. Chemical Characterization of Pure Compound (PNS-1-OR)
3. Materials and Methods
3.1. Collection and Isolation of Fungus
3.2. Morphological Identification and Deposition of Fungal Culture
3.3. Molecular Identification and Phylogeny
3.4. Analysis of Pigment Production on Different Media
3.5. Analysis of Pigment Production in Liquid Media
3.6. Fermentation and Extraction of Pigments
3.7. UV–VIS Spectroscopy Analysis of Hexane Extract
3.8. Antagonistic Activity of G. triuniae NFCCI 4873
3.9. In-vitro Antioxidant Activity of Crude Pigment
3.10. Antimicrobial Activity of Crude Hexane Extract
3.11. Antimicrobial Activity by Disc Diffusion Method
3.12. Determination of Minimum Inhibitory Concentration (MIC) and Minimum Bactericidal Concentration (MBC)
3.12.1. Preparation of Pigment Stock
3.12.2. Preparation of Standardized Inoculum
3.12.3. MIC and MBC Experiment
3.13. Dyeing of Cotton with a Crude Pigment of G. triuniae NFCCI 4873
3.13.1. Textile Fabric
3.13.2. Scouring
3.13.3. Mordanting
3.13.4. Preparation of Dye Bath
3.13.5. Dyeing
3.14. GC–MS Analysis
3.15. Purification of a Compound by HP-TLC
3.16. Chemical Characterization of Purified Orange Compound (PNS-1-OR)
4. Conclusions
Supplementary Materials
Author Contributions
Funding
Institutional Review Board Statement
Informed Consent Statement
Data Availability Statement
Acknowledgments
Conflicts of Interest
References
- Rao, M.P.; Xiao, M.; Li, W.J. Fungal and Bacterial Pigments: Secondary Metabolites with Wide Applications. Front. Microbiol. 2017, 8, 1113. [Google Scholar]
- Mansour, R. Natural Dyes and Pigments: Extraction and Applications. In Handbook of Renewable Materials for Coloration & Finishing; Scrivener Publishing LLC: Beverly, MA, USA, 2018; Volume 9, pp. 75–102. [Google Scholar]
- Ranaweera, S.J.; Ampemohotti, A.A.L.T.; Arachchige, U.S. Advantages, and Considerations for the Applications of Natural Food Pigments in the Food Industry. J. Res. Technol. Eng. 2020, 1, 8–18. [Google Scholar]
- Arora, S. Textile Dyes: Its Impact on Environment and Its Treatment. J. Bioremediation Biodegrad. 2014, 5, 1000e146. [Google Scholar] [CrossRef]
- Ardila-Leal, L.D.; Poutou-Piñales, R.A.; Pedroza-Rodríguez, A.M.; Quevedo-Hidalgo, B.E. A Brief History of Colour, The Environmental Impact of Synthetic Dyes and Removal by Using Laccases. Molecules 2021, 26, 3813. [Google Scholar] [CrossRef] [PubMed]
- Manzoor, J.; Sharma, M. Impact of Textile Dyes on Human Health and Environment. In Impact of Textile Dyes on Public Health and the Environment; IGI Global: Hershey, PA, USA, 2020; pp. 162–169. [Google Scholar]
- Caro, Y.; Venkatachalam, M.; Lebeau, J.; Fouillaud, M.; Dufossé, L. Pigments and Colorants from Filamentous Fungi. In Fungal Metabolites; Merillon, J.-M., Ramawat, K.G., Eds.; Springer International Publishing: Cham, Switzerland, 2017; pp. 499–568. [Google Scholar]
- Lagashetti, A.C.; Dufossé, L.; Singh, S.K.; Singh, P.N. Fungal Pigments and Their Prospects in Different Industries. Microorganisms 2019, 7, 604. [Google Scholar] [CrossRef] [Green Version]
- Ramesh, C.; Vinithkumar, N.V.; Kirubagaran, R.; Venil, C.K.; Dufossé, L. Multifaceted Applications of Microbial Pigments: Current Knowledge, Challenges and Future Directions for Public Health Implications. Microorganisms 2019, 7, 186. [Google Scholar] [CrossRef] [PubMed] [Green Version]
- Khan, A.A.; Alshabi, A.M.; Alqahtani, Y.S.; Alqahtani, A.M.; Bennur, R.S.; Shaikh, I.A.; Muddapur, U.M.; Shakeel Iqubal, S.M.; Mohammed, T.; Dawoud, A.; et al. Extraction and Identification of Fungal Pigment from Penicillium europium Using Different Spectral Studies. J. King Saud Univ.–Sci. 2021, 33, 101437. [Google Scholar] [CrossRef]
- Dufossé, L. Microbial Production of Food Grade Pigments. Food Technol. Biotechnol. 2006, 44, 313–323. [Google Scholar]
- Kumar, A.; Vishwakarma, H.S.; Singh, J.; Dwivedi, S.; Kumar, M. Microbial Pigments: Production and Their Applications in Various Industries. Int. J. Pharm. Chem. Biol. Sci. 2015, 5, 203–212. [Google Scholar]
- Sajid, S.; Akbar, N. Applications of Fungal Pigments in Biotechnology. Pure Appl. Biol. 2018, 7, 922–930. [Google Scholar] [CrossRef]
- Mapari, S.A.; Meyer, A.S.; Thrane, U. Evaluation of Epicoccum nigrum for Growth, Morphology, and Production of Natural Colorants in Liquid Media and on a Solid Rice Medium. Biotechnol. Lett. 2008, 30, 2183–2190. [Google Scholar] [CrossRef]
- Sibero, M.T.; Triningsih, D.W.; Radjasa, O.K.; Sabdono, A.; Trianto, A. Evaluation of Antimicrobial Activity and Identification of Yellow Pigmented Marine Sponge-Associated Fungi from Teluk Awur, Jepara, Central Java. Indones. J. Biotechnol. 2016, 21, 1–11. [Google Scholar] [CrossRef] [Green Version]
- Heo, Y.M.; Kim, K.; Kwon, S.L.; Na, J.; Lee, H.; Jang, S.; Kim, C.H.; Jung, J.; Kim, J.J. Investigation of Filamentous Fungi Producing Safe, Functional Water-Soluble Pigments. Mycobiology 2018, 46, 269–277. [Google Scholar] [CrossRef] [Green Version]
- Wang, W.; Liao, Y.; Chen, R.; Hou, Y.; Ke, W.; Zhang, B.; Gao, M.; Shao, Z.; Chen, J.; Li, F. Chlorinated Azaphilone Pigments with Anti-microbial and Cytotoxic Activities Isolated from the Deep Sea-Derived Fungus Chaetomium sp. NA–S01–R1. Mar. Drugs 2018, 16, 61. [Google Scholar] [CrossRef] [PubMed] [Green Version]
- Kalra, R.; Conlan, X.A.; Goel, M. Fungi as A Potential Source of Pigments: Harnessing Filamentous Fungi. Front. Chem. 2020, 8, 369. [Google Scholar] [CrossRef] [PubMed]
- Polak, J.; Wlizło, K.; Pogni, R.; Petricci, E.; Grąz, M.; Szałapata, K.; Osińska-Jaroszuk, M.; Kapral-Piotrowska, J.; Pawlikowska-Pawlęga, B.; Jarosz-Wilkołazka, A. Structure and Bioactive Properties of Novel Textile Dyes Synthesised by Fungal Laccase. Int. J. Mol. Sci. 2020, 21, 2052. [Google Scholar] [CrossRef] [PubMed] [Green Version]
- Sudhakar, C.; Reddy, M.K.; Rajyalakshmi, K.; Raju, K.R. Antibacterial Activity of Substituted 2-Bromo-1, 4-Dimethoxy-3H-Phenoxazin-3-Ones. J. Chem. Pharm. Res. 2016, 8, 571–574. [Google Scholar]
- Achenbach, H.; Blümm, E. Investigation of the Pigments of Pycnoporus sanguineus-Pycnosanguin and New Phenoxazin-3-Ones. Arch. Pharm. 1991, 324, 3–6. [Google Scholar] [CrossRef]
- Maskey, R.P.; Li, F.; Qin, S.; Fiebig, H.H.; Laatsch, H. Chandrananimycins A approximately C: Production of Novel Anticancer Antibiotics from A Marine Actinomadura sp. Isolate M048 by Variation of Medium Composition and Growth Conditions. J. Antibiot. 2003, 56, 622–629. [Google Scholar] [CrossRef] [Green Version]
- Mondal, A.; Bose, S.; Banerjee, S.; Patra, J.K.; Malik, J.; Mandal, S.K.; Kilpatrick, K.L.; Das, G.; Kerry, R.G.; Fimognari, C.; et al. Marine Cyanobacteria and Microalgae Metabolites—A Rich Source of Potential Anticancer Drugs. Mar. Drugs 2020, 18, 476. [Google Scholar] [CrossRef]
- Onoabedje, E.A.; Okoro, U.C.; Knight, D.W. Rapid Access to New Angular Phenothiazine and Phenoxazine Dyes. J. Heterocycl. Chem. 2017, 54, 206–214. [Google Scholar] [CrossRef]
- Kinjo, J.E.; Yokomizo, K.; Awata, Y.; Shibata, M.; Nohara, T.; Teramine, T.; Takahashi, K. Structures of Phytotoxins, AV–Toxins C, D, and E, Produced by Zonate Leaf Spot Fungus of Mulberry. Tetrahedron Lett. 1987, 28, 3697–3698. [Google Scholar] [CrossRef]
- Riddell, R.W. Permanent Stained Mycological Preparations Obtained by Slide Culture. Mycologia 1950, 42, 265–270. [Google Scholar] [CrossRef]
- Senanayake, I.C.; Rathnayaka, A.R.; Marasinghe, D.S.; Calabon, M.S.; Gentekaki, E.; Lee, H.B.; Hurdeal, V.G.; Pem, D.; Dissanayake, L.S.; Wijesinghe, S.N.; et al. Morphological Approaches in Studying Fungi: Collection, Examination, Isolation, Sporulation, and Preservation. Mycosphere 2020, 11, 2678–2754. [Google Scholar] [CrossRef]
- Srinivasan, M.C.; Chidambaram, P.; Mathur, S.B.; Neergaard, P. A Simple Method for Inducing Sporulation in Seed–Borne Fungi. Trans. Br. Mycol. Soc. 1971, 56, 31–35. [Google Scholar] [CrossRef]
- Aamir, S.; Sutar, S.; Singh, S.K.; Baghela, A. A Rapid and Efficient Method of Fungal Genomic DNA Extraction, Suitable for PCR Based Molecular Methods. Plant Pathol. Quar. 2015, 5, 74–81. [Google Scholar] [CrossRef]
- White, T.J.; Bruns, T.D.; Lee, S.; Taylor, J. Amplification and Direct Sequencing of Fungal Ribosomal RNA Genes for Phylogenetics. In PCR Protocols, A Guide to Methods and Applications; Innis, M.A., Gelfand, D.H., Sninsky, J.J., White, T.J., Eds.; Academic Press: San Diego, CA, USA, 1990; pp. 315–322. [Google Scholar]
- Vilgalys, R.; Hester, M. Rapid Genetic Identification and Mapping of Enzymatically Amplified Ribosomal DNA from Several Cryptococcus Species. J. Bacteriol. 1990, 172, 4238–4246. [Google Scholar] [CrossRef] [Green Version]
- Kumar, S.; Stecher, G.; Tamura, K. MEGA7, Molecular Evolutionary Genetics Analysis Version 7.0 for Bigger Datasets. Mol. Biol. Evol. 2016, 33, 1870–1874. [Google Scholar] [CrossRef] [Green Version]
- Nguyen, L.T.; Schmidt, H.A.; Von Haeseler, A.; Minh, B.Q. IQ–TREE: A Fast and Effective Stochastic Algorithm for Estimating Maximum-Likelihood Phylogenies. Mol. Biol. Evol. 2015, 32, 268–274. [Google Scholar] [CrossRef]
- Kornerup, A.; Wanscher, J.H. Methuen Handbook of Colour, 3rd ed.; Eyre Methuen Ltd.: London, UK, 1978; pp. 1–252. [Google Scholar]
- Velmurugan, P.; Kim, M.J.; Park, J.S.; Karthikeyan, K.; Lakshmanaperumalsamy, P.; Lee, K.J.; Park, Y.J.; Oh, B.T. Dyeing of Cotton Yarn with Five Water Soluble Fungal Pigments Obtained from Five Fungi. Fibers Polym. 2010, 11, 598–605. [Google Scholar] [CrossRef]
- Morton, D.J.; Stroube, W.H. Antagonistic and Stimulatory Effects of Soil Microorganisms Upon Sclerotium rolfsii. Phytopathology 1955, 45, 417–420. [Google Scholar]
- Rabha, A.J.; Naglot, A.; Sharma, G.D.; Gogoi, H.K.; Veer, V. In Vitro Evaluation of Antagonism of Endophytic Colletotrichum gloeosporioides Against Potent Fungal Pathogens of Camellia sinensis. Indian J. Microbiol. 2014, 54, 302–309. [Google Scholar] [CrossRef] [PubMed] [Green Version]
- Jinesh, V.K.; Jaishree, V.; Badami, S.; Shyam, W. Comparative Evaluation of Antioxidant Properties of Edible and Non–Edible Leaves of Anethum graveolens Linn. Indian J. Nat. Prod. Resour. 2010, 1, 168–173. [Google Scholar]
- Balouiri, M.; Sadiki, M.; Ibnsouda, S.K. Methods for In Vitro Evaluating Anti-microbial Activity: A Review. J. Pharm. Anal. 2016, 6, 71–79. [Google Scholar] [CrossRef] [PubMed] [Green Version]
- Devi, S.; Karuppan, P. Reddish Brown Pigments from Alternaria alternata for Textile Dyeing and Printing. Indian J. Fibre Text. Res. 2015, 40, 315–319. [Google Scholar]
- Janani, L.; Hillary, L.; Phillips, K. Mordanting Methods for Dyeing Cotton Fabrics with Dye from Albizia coriaria Plant Species. Int. J. Sci. Res. Publ. 2014, 4, 1–6. [Google Scholar]

| Samples | The Diameter of the Zone of Inhibition in Millimeters (Values are Average of Three Readings) | |||||
| E. coli MTCC 739 | B. subtilis MTCC 121 | P. aeruginosa MTCC 2453 | S. aureus MTCC 2940 | R. planticola MTCC 530 | M. luteus MTCC 2470 | |
| Hexane extract of G. triuniae NFCCI 4873 | - | 17.33 ± 1.53 | - | 18.67 ± 0.58 | 12.33 ± 0.58 | 17.33 ± 1.53 |
| Streptomycin | 23.33 ± 2.89 | 18 ± 0 | 9 ± 0 | - | 19.67 ± 0.58 | 38.66 ± 1.15 |
| Ampicillin | 18.33 ± 2.89 | 30.67 ± 2.08 | - | 14.33 ± 1.15 | 13.67 ± 0.58 | 54 ± 0 |
| Chloramphenicol | 23.33 ± 2.89 | 29 ± 1.00 | - | 26 ± 1.00 | 19 ± 1.00 | 26.67 ± 1.53 |
| Ciprofloxacin hydrochloride | 43.33 ± 2.89 | 42 ± 1.00 | 40 ± 0 | 34 ± 1.00 | 30.33 ± 0.58 | 36.67 ± 1.53 |
| Vancomycin hydrochloride | - | 23.33 ± 0.58 | - | 20 ± 1.00 | 18.67 ± 0.58 | 26.67 ± 0.58 |
| Milli-Q water | - | - | - | - | - | - |
| Methanol | - | - | - | - | - | - |
| No. | Compound Name | Retention Time | Molecular Weight | Relative Content (%) |
|---|---|---|---|---|
| 1 | Undecane | 8.361 | 156 | 0.34 |
| 2 | Unknown | 17.817 | 283 | 0.21 |
| 3 | 1,2-benzenedicarboxylic acid, bis(2-methylpropyl) ester | 18.243 | 278 | 0.40 |
| 4 | alpha-D-Mannopyranose, 5TMS derivative | 18.594 | 540 | 0.19 |
| 5 | Dibutyl phthalate | 18.717 | 278 | 0.98 |
| 6 | n-Hexadecanoic acid | 19.116 | 256 | 3.56 |
| 7 | Dibutyl phthalate | 19.189 | 278 | 0.75 |
| 8 | Phthalic acid, butyl nonyl ester | 19.386 | 348 | 0.30 |
| 9 | alpha-D-Mannopyranose, 1,2,3,4,6-pentakis-O-(trimethylsilyl)- | 19.459 | 540 | 0.28 |
| 10 | Hexadecanoic acid, trimethylsilyl ester | 19.854 | 328 | 1.75 |
| 11 | 9-Octadecenoic acid, methyl ester, (E)- | 20.401 | 296 | 0.21 |
| 12 | 9-Octadecenoic acid, (E)- | 20.801 | 282 | 17.62 |
| 13 | Octadecanoic acid | 20.989 | 284 | 2.85 |
| 14 | Unknown | 21.380 | 355 | 0.25 |
| 15 | 9-Octadecenoic acid, (E)-, TMS derivative | 21.422 | 354 | 1.37 |
| 16 | 9,12-Octadecadienoic acid (Z,Z)- | 21.550 | 280 | 0.47 |
| 17 | Unknown | 21.655 | 327 | 1.13 |
| 18 | Hexatriacontane | 21.747 | 506 | 2.71 |
| 19 | Unknown | 21.820 | 383 | 0.51 |
| 20 | Glycidyl palmitate | 22.149 | 312 | 0.53 |
| 21 | Unknown | 22.355 | 340 | 0.65 |
| 22 | Unknown | 22.697 | 355 | 28.08 |
| 23 | Unknown | 22.854 | 411 | 30.35 |
| 24 | Unknown | 23.126 | 397 | 2.97 |
| 25 | 9-octadecenoic acid, 1,2,3-propanetriyl ester, | 23.990 | 884 | 1.56 |
| Position | 1,2-dimethoxy-3H-phenoxazin-3-one from G. triuniae NFCCI 4873 | 1,2-dimethoxy-3H-phenoxazin-3-one Reported from A. viticola | ||
|---|---|---|---|---|
| δC | δH (J in Hz) | δC | δH (J in Hz) | |
| 1 | 145.2 C | - | 145.1 C | - |
| 2 | 145.8 C | - | 145.9 C | - |
| 3 | 181.8 C=O | - | 181.8 C=O | - |
| 4 | 104.6 CH | 6.23, s | 104.7 CH | 6.23, s |
| 4a | 147.2 C | - | 147.3 C | - |
| 5a | 143.4 C | - | 143.5 C | - |
| 6 | 115.9 CH | 7.33, dd (8.1, 1.07) | 116.0 CH | 7.33, dd (8.2) |
| 7 | 132.2 CH | 7.54, td (7.7, 1.37) | 132.2 CH | 7.53, td (8.2) |
| 8 | 125.3 CH | 7.39, td (7.71, 1.37) | 125.3 CH | 7.39, td (8.2) |
| 9 | 130.3 CH | 7.92, dd (7.93, 1.53) | 130.3 CH | 7.92, dd (8.2) |
| 9a | 132.6 C | 132.7 C | - | |
| 10a | 147.2 C | 147.8 C | - | |
| 1-OMe | 62.2 CH3 | 4.12, s | 62.3 CH3 | 4.12, s |
| 2-OMe | 61.1 CH3 | 4.14, s | 61.2 CH3 | 4.14, s |
| Sr. No. | Fungal Culture | Strain | GenBank Accession No. | |
|---|---|---|---|---|
| ITS | LSU | |||
| 1 | Gonatophragmium triuniae | NFCCI 4873 | MW193329 | MW144438 |
| 2 | Gonatophragmium triuniae | CBS 138901 | NR_137932 | NG_058117 |
| 3 | Gonatophragmium epilobii | CBS 122271 | MH863183 | MH874728 |
| 4 | Acrospermum sp. | SGSF153 | MK335823 | MK754265 |
| 5 | Acrospermum longisporium | MFLU 17-2849 | - | NG_064506 |
| 6 | Acrospermum gramineum | M152 | - | EU940085 |
| 7 | Acrospermum compressum | M151 | - | EU940084 |
| 8 | Pseudovirgaria grisea | CPC 19130 | JF957607 | JF957612 |
| 9 | Pseudovirgaria hyperparasitica | CPC 10702 | EU041765 | EU041822 |
| 10 | Pseudovirgaria hyperparasitica | CPC 10704 | EU041766 | EU041823 |
| 11 | Pseudovirgaria hyperparasitica | CPC 10753 | EU041767 | EU041824 |
| 12 | Pseudovirgaria grisea | CPC 19126 | JF957605 | JF957610 |
| 13 | Pseudovirgaria grisea | CPC 19128 | JF957606 | JF957611 |
| 14 | Dyfrolomyces sinensis | MFLU 17-0777 | - | NG_064507 |
| 15 | Dyfrolomyces sinensis | MFLUCC 17-1344 | - | MG836699 |
| 16 | Dyfrolomyces tiomanensis | NTOU3636 | - | KC692156 |
| 17 | Dyfrolomyces rhizophorae | JK 5456A | - | GU479799 |
| 18 | Dyfrolomyces thamplaensis | MFLUCC 15-0635 | - | KX925435 |
| 19 | Eremomyces bilateralis | CBS 781.70 | NR_145364 | NG_059206 |
Publisher’s Note: MDPI stays neutral with regard to jurisdictional claims in published maps and institutional affiliations. |
© 2022 by the authors. Licensee MDPI, Basel, Switzerland. This article is an open access article distributed under the terms and conditions of the Creative Commons Attribution (CC BY) license (https://creativecommons.org/licenses/by/4.0/).
Share and Cite
Lagashetti, A.C.; Singh, S.K.; Dufossé, L.; Srivastava, P.; Singh, P.N. Antioxidant, Antibacterial and Dyeing Potential of Crude Pigment Extract of Gonatophragmium triuniae and Its Chemical Characterization. Molecules 2022, 27, 393. https://doi.org/10.3390/molecules27020393
Lagashetti AC, Singh SK, Dufossé L, Srivastava P, Singh PN. Antioxidant, Antibacterial and Dyeing Potential of Crude Pigment Extract of Gonatophragmium triuniae and Its Chemical Characterization. Molecules. 2022; 27(2):393. https://doi.org/10.3390/molecules27020393
Chicago/Turabian StyleLagashetti, Ajay C., Sanjay K. Singh, Laurent Dufossé, Pratibha Srivastava, and Paras N. Singh. 2022. "Antioxidant, Antibacterial and Dyeing Potential of Crude Pigment Extract of Gonatophragmium triuniae and Its Chemical Characterization" Molecules 27, no. 2: 393. https://doi.org/10.3390/molecules27020393
APA StyleLagashetti, A. C., Singh, S. K., Dufossé, L., Srivastava, P., & Singh, P. N. (2022). Antioxidant, Antibacterial and Dyeing Potential of Crude Pigment Extract of Gonatophragmium triuniae and Its Chemical Characterization. Molecules, 27(2), 393. https://doi.org/10.3390/molecules27020393

